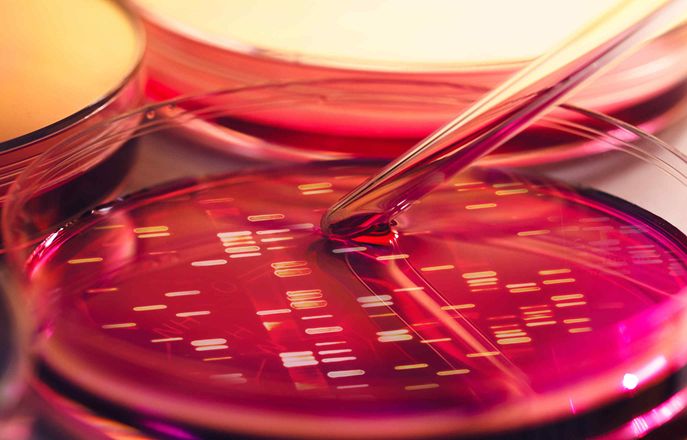

Committees
Links to ICREC and SETREC
The majority of the projects reviewed by the Research Ethics Committees are hosted in the UK, with a few hosted abroad. The Principal Investigator must always be employed by Imperial College London. Low-level projects without high risks can be reviewed by the RGI team, any high-risk projects must be reviewed by full Committee these include but are not limited to:
- Research which is invasive
- Research where the subject matter is sensitive
- Research which includes prisoners and young offenders
- Research which involves individuals in an overtly dependent situation (people in care)
- Research which takes place overseas, these may also require local ethical approval (local approval is necessary but not sufficient on its own)
- Research which involves vulnerable groups; children or adults who are unable to consent, the mentally ill and individuals with learning difficulties
The research ethics risk checklist [Word] will help determine whether your study is considered low risk (eligible for fast track approval) or high risk (for full committee review).
High risk and low risk studies
Find out more about our two key committees: